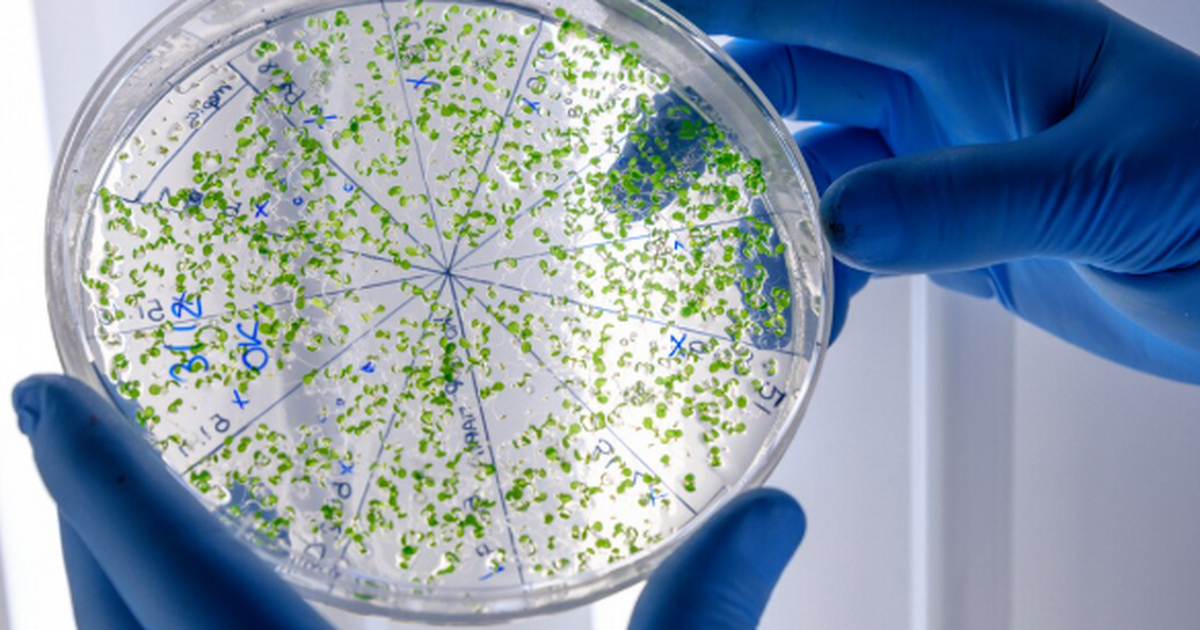
Китайские микробиологи открыли новый бактериофа...

Выявлен бактериофаг W5, уничтожающий сальмонеллу, устойчивую к антибиотикам
freepik
Китайские микробиологи открыли новый бактериофаг из семейства W5, который эффективно уничтожает широкий спектр штаммов сальмонеллы, включая устойчивые к антибиотикам, сообщили в пресс-службе Американского микробиологического общества.
Профессор Гоу Хуэйтянь из Сельскохозяйственного университета Ганьсу отметил, что вирус действует как точная «ракета», уничтожая колонии сальмонеллы в продуктах питания и на упаковках. Он способен быстро размножаться, период инкубации составляет всего 22 минуты. Бактериофаг предотвращает образование биопленок, защищающих бактерии от лекарств, что делает его перспективным средством для защиты пищевой продукции.
Ранее бактериофаги использовались до появления антибиотиков, но сейчас их изучение возобновлено из-за распространения резистентных штаммов. Открытие W5 открывает новые возможности биологической защиты от сальмонеллеза.
Больше новостей и эксклюзивных видео смотрите в канале Самара Онлайн 24 в MAX.
Читайте также:
- Альтернатива Telegram: В России становится популярным новый мессенджер KakaoTalk
- Надо 21 раз в месяц: Названа привычка, которая может снизить риск рака простаты
- С апреля всё поменяется: новые правила на Ozon и Wildberries — что важно знать покупателям
- Пасха-2026: яйца цвета бургунди с блёстками — новый тренд, который поразит всех
- Рабочую неделю сокращают до 4 дней — что это значит для сотрудников и экономики РФ



